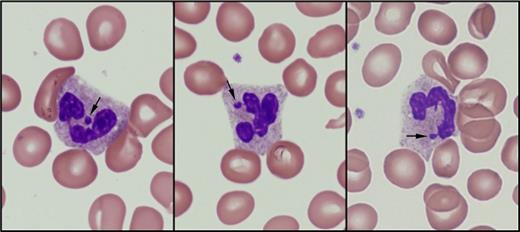
Yaseen Image Challenge Fig 2. / Yaseen Image Challenge Fig 2

A peripheral blood smear review was requested on a 58-year-old man with a history of plasma cell myeloma. Representative images from the blood smear are shown below.
Yaseen Image Challenge Fig 1
A. Bortezomib, lenalidomide, dexamethasone
B. Carfilzomib, lenalidomide, dexamethasone
C. Autologous stem cell transplantation
D. Allogeneic stem cell transplantation
Sorry, that was not the preferred response.
Correct!
Yaseen Image Challenge Fig 2
Microscopic examination of the Giemsa-stained peripheral smear revealed an unusual finding: 11 percent of the patient’s neutrophils contained a drumstick-like appendage of chromatin (indicated by arrows). This appendage was recognized as sex chromatin, the portion of the nucleus that contains the inactivated X chromosome in approximately 1 to 17 percent of neutrophils in healthy (46, XX) female patients.1 Neutrophils of normal males (46, XY) do not contain this appendage. A review of the patient’s medical record revealed that he had undergone mini-matched unrelated donor allogeneic stem cell transplantation. There were no significant complications, and the patient’s bone marrow after the transplant was slightly hypocellular with no evidence of plasma cell myeloma. Cytogenetic testing of the bone marrow revealed that 20/20 metaphases had a 46, XX karyotype, consistent with female donor origin.
References
References
Dr. Yaseen indicated no relevant conflicts of interest.